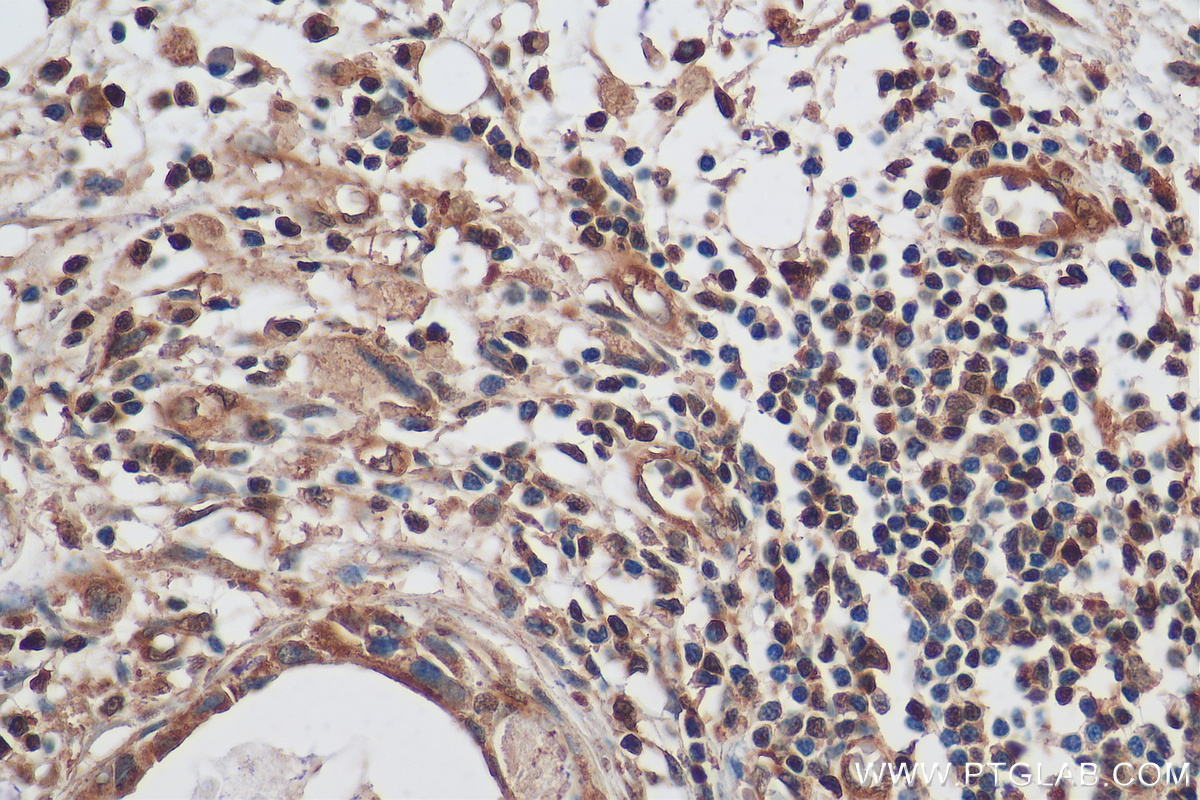

验证数据展示
经过测试的应用
| Positive WB detected in | HeLa cells, HEK-293 cells, Jurkat cells, K-562 cells, MCF-7 cells |
| Positive IP detected in | HeLa cells |
| Positive IHC detected in | human breast cancer tissue, human colon tissue, human liver cancer tissue, human stomach tissue Note: suggested antigen retrieval with TE buffer pH 9.0; (*) Alternatively, antigen retrieval may be performed with citrate buffer pH 6.0 |
| Positive IF/ICC detected in | HepG2 cells, TNF alpha treated HT-1080 cells |
推荐稀释比
| 应用 | 推荐稀释比 |
|---|---|
| Western Blot (WB) | WB : 1:1000-1:4000 |
| Immunoprecipitation (IP) | IP : 0.5-4.0 ug for 1.0-3.0 mg of total protein lysate |
| Immunohistochemistry (IHC) | IHC : 1:50-1:500 |
| Immunofluorescence (IF)/ICC | IF/ICC : 1:50-1:500 |
| It is recommended that this reagent should be titrated in each testing system to obtain optimal results. | |
| Sample-dependent, Check data in validation data gallery. | |
产品信息
10745-1-AP targets NF-κB p65 in WB, IHC, IF/ICC, IP, CoIP, chIP, ELISA applications and shows reactivity with human samples.
| 经测试应用 | WB, IHC, IF/ICC, IP, ELISA Application Description |
| 文献引用应用 | WB, IHC, IF, IP, CoIP, chIP, ELISA |
| 经测试反应性 | human |
| 文献引用反应性 | human, mouse, rat, rabbit, monkey, chicken, zebrafish, sheep, goat, fish |
| 免疫原 |
CatNo: Ag1199 Product name: Recombinant human p65; RELA protein Source: e coli.-derived, PGEX-4T Tag: GST Domain: 1-220 aa of BC011603 Sequence: MDELFPLIFPAEPAQASGPYVEIIEQPKQRGMRFRYKCEGRSAGSIPGERSTDTTKTHPTIKINGYTGPGTVRISLVTKDPPHRPHPHELVGKDCRDGFYEAELCPDRCIHSFQNLGIQCVKKRDLEQAISQRIQTNNNPFQVPIEEQRGDYDLNAVRLCFQVTVRDPSGRPLRLPPVLSHPIFDNRAPNTAELKICRVNRNSGSCLGGDEIFLLCDKVQ 种属同源性预测 |
| 宿主/亚型 | Rabbit / IgG |
| 抗体类别 | Polyclonal |
| 产品类型 | Antibody |
| 全称 | v-rel reticuloendotheliosis viral oncogene homolog A (avian) |
| 别名 | NF κB, p65, p65; RELA, RELA, NF Kappa B |
| 计算分子量 | 65 kDa |
| 观测分子量 | 65 kDa |
| GenBank蛋白编号 | BC011603 |
| 基因名称 | NF-κB p65 |
| Gene ID (NCBI) | 5970 |
| RRID | AB_2178878 |
| 偶联类型 | Unconjugated |
| 形式 | Liquid |
| 纯化方式 | Antigen affinity purification |
| UNIPROT ID | Q04206 |
| 储存缓冲液 | PBS with 0.02% sodium azide and 50% glycerol, pH 7.3. |
| 储存条件 | Store at -20°C. Stable for one year after shipment. Aliquoting is unnecessary for -20oC storage. |
背景介绍
Nuclear factor k B (NF-kB) is a sequence-specific DNA-binding protein complex which regulates the expression of viral genomes, including the human immunodeficiency virus, and a variety of cellular genes, particularly those involved in immune and inflammatory responses. The members of the NF-kB family in mammalian cells include the proto-oncogene c-Rel,p50/p105 (NFkB1), p65 (RelA), p52/p100 (NFkB2), and RelB. All of these proteins share a conserved 300-amino acid region known as the Rel homology domain which is responsible for DNA binding, dimerization, and nuclear translocation of NF-kB. The p65 subunit is a major component of NF-kB complexes and is responsible for trans-activation. NF-kB heterodimeric p65-p50 and p65-c-Rel complexes are transcriptional activators. The NF-kB p65-p65 complex appears to be involved in invasin-mediated activation of IL-8 expression. The inhibitory effect of IkB upon NF-kB the cytoplasm is exerted primarily through the interaction with p65. p65 shows a weak DNA-binding site which could contribute directly to DNA binding in the NF-kB complex. It associates with chromatin at the NF-kB promoter region via association with DDX1. This antibody is a rabbit polyclonal antibody raised against residues near the N terminus of human RELA.
实验方案
| Product Specific Protocols | |
|---|---|
| IF protocol for NF-κB p65 antibody 10745-1-AP | Download protocol |
| IHC protocol for NF-κB p65 antibody 10745-1-AP | Download protocol |
| IP protocol for NF-κB p65 antibody 10745-1-AP | Download protocol |
| WB protocol for NF-κB p65 antibody 10745-1-AP | Download protocol |
| Standard Protocols | |
|---|---|
| Click here to view our Standard Protocols |
发表文章
| Species | Application | Title |
|---|---|---|
Nat Immunol Sparcl1 mitigates abdominal aortic aneurysm through inhibiting lymphangiogenesis-mediated TLS formation | ||
Bioact Mater Silicate ions as soluble form of bioactive ceramics alleviate aortic aneurysm and dissection | ||
ACS Nano A Therapeutic System Regulating Iron Metabolism in CD63+ Macrophage Subsets Activates Anti-tumor Immunity for Bone Metastasis Therapy | ||
Mol Cell Serine synthesis sustains macrophage IL-1β production via NAD+-dependent protein acetylation |